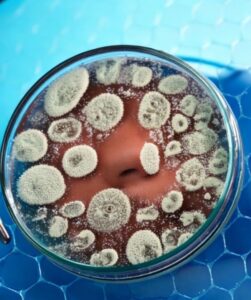

Stem Cell Treatment for SMA: A Pathway to Understanding Your Options
Navigating a diagnosis of Spinal Muscular Atrophy (SMA) can be one of the most challenging journeys a family faces. The search for clear, reliable information about potential pathways, including the evolving field of regenerative medicine, is often overwhelming. At Regencord in Pereira, Colombia, we understand this journey. This comprehensive guide aims to illuminate the current understanding of stem cell research for SMA, discussing its potential and the ethical considerations involved, while also presenting the unique advantages of exploring care pathways in Pereira, Colombia.
Our commitment is to empower you with knowledge, addressing common anxieties and logistical concerns with transparency and compassion. We focus on education, verifiable facts, and a patient-centric approach to help you make truly informed decisions for yourself or your loved one.
Key Takeaways for Your Journey
- SMA is a Complex Genetic Condition: Understanding the fundamental science behind spinal muscular atrophy is crucial for evaluating potential pathways.
- Stem Cell Research is Evolving: While not a widely approved “cure,” stem cell research, including approaches like motor neuron rescue and intrathecal stem cell applications, represents a significant area of scientific inquiry for SMA.
- Ethical Considerations are Paramount: Responsible exploration of regenerative medicine demands a clear distinction between approved treatments and investigational approaches, emphasizing patient safety and transparent communication.
- Colombia Offers a Unique Care Environment: Pereira, Colombia, provides a blend of modern medical infrastructure, highly trained medical professionals, and a supportive, holistic environment for those considering international care.
- Patient Advocacy is Key: Navigating complex medical decisions and international travel is made simpler with dedicated support that guides you through every step, from initial inquiry to post-treatment considerations.
The Stakes & Critical Implications of Spinal Muscular Atrophy (SMA): Navigating a Complex Diagnosis

Spinal Muscular Atrophy (SMA) is a group of genetic disorders that affect the motor neurons in the spinal cord, leading to muscle weakness and wasting. This progressive condition can significantly impact mobility, breathing, and swallowing, affecting individuals from infancy through adulthood depending on the type (SMA Type 1, 2, 3, or 4). The World Health Organization (WHO) and the U.S. National Institutes of Health (NIH) both highlight SMA as a leading genetic cause of infant mortality and a significant contributor to disability in childhood, underscoring the urgency and importance of continued research and supportive care.
The core challenge in SMA lies in the deficiency of a protein called Survival Motor Neuron (SMN), which is vital for the health and function of motor neurons. Without sufficient SMN protein, these nerve cells degenerate, leading to the weakening of muscles responsible for movement. The implications extend beyond physical challenges, often impacting a family’s emotional and financial well-being. This profound impact drives many to explore all available avenues, including emerging research in regenerative medicine and approaches focused on motor neuron rescue.
Understanding the current scientific landscape, including the distinction between established treatments and ongoing research, is essential. This forms the basis for informed decision-making for those exploring pathways that may offer hope for improved quality of life or disease management.
Understanding Stem Cell Research for SMA: A Glimpse into Potential Pathways

The field of regenerative medicine, particularly stem cell research, has garnered significant interest for conditions like SMA due to the potential of these cells to repair or replace damaged tissues, protect existing cells, and modulate immune responses. For SMA, the primary focus of stem cell research revolves around strategies for motor neuron rescue, neuroprotection, and potentially serving as a genetic therapy adjunct.
What are Stem Cells?
Stem cells are unique cells with the remarkable ability to develop into many different cell types in the body during early life and growth. In many tissues, they serve as a sort of internal repair system, dividing essentially without limit to replenish other cells as long as the person or animal is still alive. For SMA, researchers are investigating various types of stem cells, including mesenchymal stem cells (MSCs) and neural progenitor cells, for their potential to:
- Replace Damaged Motor Neurons: Theoretically, stem cells could differentiate into new, healthy motor neurons, replacing those lost in SMA.
- Provide Neuroprotection: Stem cells may release factors that protect existing motor neurons from degeneration, slowing disease progression.
- Modulate Inflammation: Some stem cells possess immunomodulatory properties that could reduce inflammation around motor neurons, which may contribute to their damage.
- Act as a Delivery Vehicle: Genetically modified stem cells could potentially deliver therapeutic genes or proteins to the affected areas, acting as a genetic therapy adjunct.
Studies indexed on PubMed and registered on ClinicalTrials.gov show ongoing investigations into these mechanisms, often exploring various delivery methods, including intrathecal stem cells, where cells are injected directly into the cerebrospinal fluid to reach the spinal cord more effectively.
Current Research Landscape and Ethical Considerations
It is important to emphasize that while promising, stem cell treatments for SMA are largely considered investigational or within the realm of ongoing clinical trials. The U.S. National Institutes of Health (NIH) and various peer-reviewed journals consistently highlight the need for robust, well-designed studies to establish safety and efficacy before widespread clinical application. Regulatory bodies like the U.S. Food and Drug Administration (FDA) and the European Medicines Agency (EMA) have rigorous approval processes for new medical treatments, particularly those involving advanced cell therapies.
Our approach at Regencord aligns with these principles. We focus on providing information about scientifically grounded, ethically sound regenerative pathways, understanding that the journey for SMA involves careful consideration of all available research and options. We do not offer unproven “cures” but rather focus on responsible exploration of advanced care modalities within established regulatory frameworks, such as those overseen by the Colombian Ministry of Health and INVIMA.
The Conventional Approach in Many Regions and Evolving Options

For decades, conventional management of Spinal Muscular Atrophy focused primarily on supportive care to manage symptoms and improve quality of life. This included physical therapy, occupational therapy, respiratory support, and nutritional management. However, significant breakthroughs in genetic therapies have transformed the landscape for SMA in recent years.
In many regions, including the USA and Canada, the standard of care now often includes disease-modifying therapies that target the genetic root cause of SMA. These therapies, such as nusinersen (Spinraza), onasemnogene abeparvovec (Zolgensma), and risdiplam (Evrysdi), have shown the ability to improve motor function and survival, especially when administered early. These treatments are approved by bodies like the FDA and EMA and represent a significant advance, offering hope to many families.
While these advancements are profound, they also present new considerations regarding access, cost, and the specific patient profile for whom they are most effective. Patients and families continue to explore all potential avenues to complement existing therapies or to address unmet needs, which often leads to an interest in regenerative medicine, including potential motor neuron rescue strategies. It’s important to understand how stem cell research fits into this evolving landscape – as a field of active investigation seeking to provide additional or complementary benefits, rather than a direct replacement for approved genetic therapies.
The Pereira, Colombia Advantage: A Holistic Approach to Patient Care
When considering advanced medical pathways, the choice of location for care extends beyond just the clinical procedure itself. It encompasses the entire patient experience, from logistical support to the healing environment. Pereira, Colombia, has emerged as a compelling destination for those exploring innovative care options, offering distinct advantages that foster a supportive and comprehensive patient journey.
Modern Infrastructure and High Standards of Care
Colombia has invested significantly in its healthcare infrastructure, particularly in cities like Pereira. The region boasts modern medical facilities equipped with advanced technology and highly trained medical professionals who often receive international education and continuous professional development. The Colombian Ministry of Health and INVIMA (Colombia’s National Food and Drug Surveillance Institute) oversee stringent regulations for medical practices and pharmaceuticals, ensuring a commitment to patient safety and ethical standards. This robust regulatory environment provides a framework of confidence for patients seeking care.
As synthesized from deep experience in facilitating international medical care, many families seeking advanced care for conditions like SMA often face a bewildering maze of information, compounded by the emotional toll of the diagnosis. They crave not just treatment, but a clear, compassionate pathway that demystifies the process, from initial inquiry to post-treatment support, ensuring every step is understood and managed.
A Holistic and Supportive Environment
Pereira, often referred to as “The Pearl of Otún,” is nestled in Colombia’s Coffee Axis, a region known for its breathtaking natural beauty, pleasant climate, and warm, welcoming culture. This environment can play a significant role in a patient’s overall well-being and recovery process. The serene surroundings and a slower pace of life, compared to bustling metropolises, often contribute to a calming atmosphere conducive to healing.
Patients often discover that beyond the clinical excellence, the warm, supportive culture and accessible travel logistics provide a holistic healing backdrop often overlooked in more traditional medical tourism destinations. The accessibility of the city, with its international airport, simplifies travel arrangements for patients and their families, reducing the inherent stress associated with international medical travel.
Personalized Patient Journey and Advocacy
At Regencord, our focus is on providing a deeply personalized and supported patient journey. This includes comprehensive assistance with travel logistics, accommodation, local transportation, language support, and seamless coordination of medical records. Our team understands the unique needs of international patients and strives to create an environment where the focus can remain on health and recovery, rather than logistical hurdles.
This commitment to a holistic and patient-centered experience, combined with a commitment to ethical, evidence-informed practices in regenerative medicine pathways, sets Pereira, Colombia, apart as a thoughtful choice for those exploring advanced care options for conditions like spinal muscular atrophy.
Introducing the “Regencord Patient Journey Compass”: Your Guide to Informed Decisions

Navigating the complexities of a rare condition like SMA and exploring potential regenerative pathways requires a clear roadmap. To assist you in this crucial journey, the team at Regencord has developed the Regencord Patient Journey Compass – a practical, branded resource designed to help you organize your thoughts, understand the process, and feel confident in your decision-making.
This comprehensive checklist and guide provides a structured approach to:
- Information Gathering: Questions to ask about different care pathways, regulatory status, and the scientific basis of regenerative approaches.
- Personal Assessment: A framework to evaluate your specific situation, needs, and goals for care.
- Logistical Planning: Practical steps for considering international medical care, including travel, accommodation, and support services.
- Ethical Scrutiny: Guidance on how to assess the ethical commitments and transparency of any potential provider.
The Regencord Patient Journey Compass empowers you to move from uncertainty to clarity, ensuring you have the necessary tools to ask the right questions and evaluate your options comprehensively.
Our Regenerative Philosophy & Patient-Centered Approach
At Regencord in Pereira, Colombia, our philosophy is rooted in ethical practice, scientific integrity, and profound respect for the patient’s journey. We understand that exploring advanced regenerative pathways, particularly for conditions as serious as spinal muscular atrophy, requires immense trust and clarity. We do not promise definitive outcomes or offer “cures.” Instead, our approach is centered on facilitating access to regenerative medicine pathways that are grounded in a commitment to patient safety, rigorous assessment, and an unwavering adherence to ethical guidelines.
Our team believes in:
- Education First: Providing comprehensive, understandable information about the current state of regenerative medicine research, helping patients distinguish between established science and ongoing investigation.
- Personalized Assessment: Each patient’s journey is unique. We conduct thorough, confidential case reviews to determine if an individual is a suitable candidate for the regenerative pathways available, based on their specific medical history and needs.
- Transparency: Clearly outlining the process, potential considerations, and the regulatory framework within which we operate in Colombia, ensuring patients are fully informed every step of the way.
- Supportive Environment: Beyond the medical aspects, we prioritize the emotional and logistical well-being of our patients and their families, offering comprehensive support services to make the experience as seamless and comfortable as possible.
- Ethical Stewardship: Our commitment is to operate within the highest ethical standards, guided by scientific principles and the well-being of those we serve, without making unsubstantiated claims.
This philosophy ensures that any decision made with our team is an informed, deliberate, and ethically sound one, empowering patients to confidently explore their options.
Overcoming Common Hesitations: Why Seeking Clarity is a Strategic Advantage
The decision to explore advanced care options, especially internationally, can be fraught with questions and uncertainties. We acknowledge these concerns and believe that addressing them directly with clear, verifiable information is a strategic advantage for patients seeking clarity.
“Is receiving medical care in Colombia safe or legitimate for SMA?”
This is a common and entirely valid concern. Colombia’s medical sector has seen substantial growth and adherence to international standards. The commitment to patient safety and quality is upheld by the Colombian Ministry of Health and INVIMA, which rigorously regulates medical facilities and practices. Many medical professionals in Colombia receive training abroad and operate within modern, well-equipped hospitals. Pereira, in particular, offers a peaceful and well-regarded medical community. Our focus is on pathways that operate within these verifiable regulatory frameworks, ensuring an emphasis on ethical and responsible care.
“This sounds too complicated and overwhelming. I wouldn’t know where to start.”
We understand that the idea of international travel for medical care, especially for a complex condition like SMA, can feel daunting. This is precisely why our patient advocacy team is integral to the Regencord experience. We transform the perceived complexity into a clear, manageable, step-by-step pathway. From assisting with travel logistics and accommodation to coordinating medical records and providing language support, our team is dedicated to guiding you and your family through every phase of the journey, making the process as smooth and stress-free as possible.
“Is stem cell treatment for SMA truly viable, or is it too experimental?”
The field of regenerative medicine is dynamic. For SMA, while traditional stem cell treatments are not yet universally approved as standard care, research into motor neuron rescue, genetic therapy adjuncts, and intrathecal stem cells continues globally (as highlighted by institutions like NIH and ongoing ClinicalTrials.gov studies). Our approach at Regencord involves a careful assessment of each patient’s case, considering existing scientific literature, and offering pathways that align with ethical research and responsible innovation within Colombia’s regulatory context. We prioritize clear communication about what is known, what is still investigational, and what can be realistically considered, without making unverified claims.
“What about the cost? Will it be affordable?”
Financial considerations are always significant. While we cannot guarantee specific affordability without a comprehensive case review, international medical care can sometimes offer different value propositions compared to healthcare systems in regions like the USA, Canada, or the UK. Our process begins with a confidential review where we can discuss the comprehensive scope of care and associated considerations specific to your situation. This transparency ensures that you have a clear understanding of potential costs and the services included, allowing you to make a financially informed decision.
Seeking clarity on these points is not just a necessity; it’s a strategic move to regain control and make empowered decisions about your health journey.
Glossary of Key Terms
- Spinal Muscular Atrophy (SMA): A genetic disorder that causes muscle weakness and wasting due to the loss of motor neurons.
- Motor Neurons: Nerve cells that extend from the brain or spinal cord to muscles, controlling their movement. Their degeneration is central to SMA.
- Stem Cells: Undifferentiated biological cells that can divide to produce more stem cells and differentiate into specialized cells.
- Regenerative Medicine: A branch of medicine focused on developing methods to regrow, repair, or replace damaged or diseased cells, organs, or tissues.
- Intrathecal: A method of administering substances directly into the spinal canal or into the subarachnoid space so that it reaches the cerebrospinal fluid (CSF). Often explored for neurological conditions.
- Genetic Therapy Adjunct: A therapy designed to complement or enhance the effects of a primary genetic treatment.
- Neuroprotection: Strategies and substances that preserve the structure and function of neurons, aiming to prevent or slow neuronal degeneration.
- INVIMA: Colombia’s National Food and Drug Surveillance Institute, responsible for regulating health products, including medical devices and biological therapies.
- Patient Journey: The entire experience of a patient through the healthcare system, encompassing all interactions and steps from initial symptoms to recovery or long-term management.
Frequently Asked Questions About Stem Cell Research for SMA & Pathways in Colombia
- What exactly is Spinal Muscular Atrophy (SMA)?
- SMA is a genetic disease affecting the motor neurons, leading to progressive muscle weakness. It’s caused by a problem with the SMN1 gene, which is crucial for producing a protein essential for motor neuron health. The severity varies depending on the type of SMA.
- Is stem cell treatment for SMA an approved therapy?
- Currently, stem cell treatments for SMA are largely considered investigational and are the subject of ongoing research and clinical trials worldwide, as documented by organizations like NIH and on ClinicalTrials.gov. They are not broadly approved as standard therapies by major regulatory bodies like the FDA or EMA. Our team focuses on ethical, evidence-informed pathways within Colombian regulatory frameworks.
- How does Regencord approach regenerative pathways for conditions like SMA?
- At Regencord, our approach is educational and patient-centric. We provide comprehensive information about the current scientific understanding of regenerative medicine for conditions like SMA, including concepts like motor neuron rescue. We facilitate access to pathways within Colombia that prioritize ethical conduct, patient safety, and transparent communication, ensuring thorough patient assessment and personalized consideration of options.
- What is the process for exploring care with the team at Regencord?
- The process typically begins with a confidential case review. You would provide your medical history and diagnostic information. Our team then assesses your individual situation to determine if you are a potential candidate for the regenerative medicine pathways available through our affiliated medical providers in Pereira, Colombia. We then guide you through the next steps, addressing all your questions.
- What are the benefits of seeking care in Pereira, Colombia?
- Pereira offers a compelling combination of modern medical infrastructure, highly trained medical professionals, stringent regulatory oversight by INVIMA, and a supportive, naturally beautiful environment. Beyond clinical excellence, our dedicated patient advocacy team assists with all logistical aspects, creating a seamless and compassionate journey for international patients.
- How does your team assist with international patients?
- Our patient advocacy team provides comprehensive support, including assistance with travel arrangements, accommodation, local transportation, medical records transfer, and language interpretation services. Our goal is to alleviate logistical burdens so you can focus entirely on your health journey.
Take the Next Step: Discover Your Options with Clarity
The journey with Spinal Muscular Atrophy requires thoughtful consideration and access to the most current, reliable information. If you or a loved one are exploring regenerative medicine pathways and wish to understand how the team at Regencord in Pereira, Colombia, can support your journey, we are here to help.
Discover if you are a candidate for the regenerative medicine pathways available through the team at Regencord in Pereira, Colombia. Contact us for a confidential case review. We are committed to providing transparent, ethical, and compassionate guidance every step of the way.



